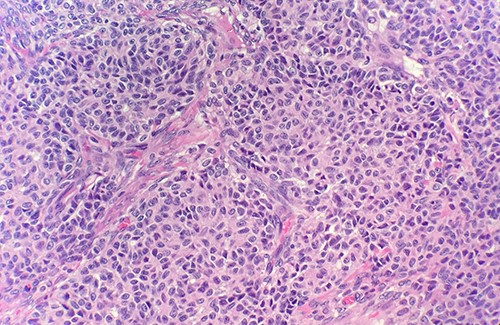
Microscopic examination of ovary shows solid growth of tumor cells with angulated pale nuclei and nuclei grooves (H&E ×40).

-
PDF
- Split View
-
Views
-
Cite
Cite
Sarah M Abuali, Armand Asarian, Philip Xiao, Synchronous granulosa cell tumor of the ovary and endometrial adenocarcinoma, Journal of Surgical Case Reports, Volume 2022, Issue 4, April 2022, rjac109, https://doi.org/10.1093/jscr/rjac109
- Share Icon Share
Abstract
Granulosa cell tumors of the ovary are sex cord stromal tumors. Sex cord stromal tumors make up 8% of ovarian tumors. Ninety percent of sex cord stromal tumors of the ovary are granulosa cell tumors. There are two types of granulosa cell tumors: juvenile and an adult type (Jamieson and Fuller. Molecular pathogenesis of granulosa cell tumors of the ovary. Endocr Rev 2012;33:109–44). This article provides a literature review outlining histopathology, immunocytochemistry and cytogenic characteristics of adult granulosa cell tumor of the ovary and a case report of synchronous adult granulosa cell tumor of the ovary and endometrial adenocarcinoma.
INTRODUCTION
Granulosa cell tumors of the ovary are rare [1]. Adult granulosa cell tumors of the ovary are indolent but also have high reoccurrence [1]. Reoccurrence is often associated with poor prognosis [1]. Characteristics such as stage, tumor size and mitotic index can help predict prognosis [2]. Although synchronous primary endometrial and ovarian tumors are also uncommon there are studies that have shown they are not as rare that previously thought [3]. A study by AlHilli et al. showed that ~3% of patients with a primary endometrial tumor also had a concurrent primary ovarian tumor [3].
CASE REPORT
This a case of a 65-year-old female with a past medical history of Hypertension, Diabetes Mellitus Type 2 and uterine bleeding. Endometrial biopsy showed endometrial adenocarcinoma, endometrioid type, FIGO Grade 2.
Patient was admitted for hysterectomy for endometrial carcinoma. There is a mass lesion measuring 4.3 × 4 cm located in right ovary indicating metastatic from uterine endometrial primary on image study. Microscopic examination of endometrial reveals endometrial adenocarcinoma, endometrioid type, FIGO Grade 2 (Fig. 1). Microscopic examination of ovary shows solid growth of tumor cells with angulated pale nuclei and nuclei grooves (Fig. 2). Tumor cells are positive for CD56, CD99, Calretinin (Fig. 3) and inhibin, combined with morphological features; this immunoprofile supports the diagnosis of granulosa cell tumor, adult type.

Microscopic examination of endometrial reveals endometrial adenocarcinoma, endometrioid type, FIGO Grade 2 (H&E ×20).
Microscopic examination of ovary shows solid growth of tumor cells with angulated pale nuclei and nuclei grooves (H&E ×40).

Tumor cells are positive for Calretinin by immunohistochemical stain (IHC ×40).
DISCUSSION
Adult granulosa cell tumor of the ovary, often unilateral, has an average size of 12 cm, is tan, gray or yellow in color, contains solid and cystic components and sometimes hemorrhagic fluid [1, 2, 4]. The granulosa cells appear small, pale and round or oval [2]. Further histologic examination reveals coffee bean grooved nuclei, stromal thecal cells and fibroblasts [1, 4]. Call-Exner bodies are also a key feature, which are collections of fluid and debris [1, 2]. Immunocytochemistry is positive for vimentin, inhibin, calretinin and CD56 [4]. Reticulin only stains around granulosa cells [4]. Pilsworth et al. study examined the genetic profile of adult granulosa cell tumors of the ovary [5]. Eighty-three cases were confirmed to have FOXL2 driver mutation [5]. Target sequencing also revealed TERT C228T promotor mutations, which is often associated with tumor progression or reoccurrence [5].
Although granulosa cell tumors are hormonally active tumors, patients often present with nonspecific symptoms; currently there are no diagnostic imaging criteria for these tumors [6]. Differential diagnosis includes hypercalcemic small cell carcinoma, adenocarcinoma, ovarian thecoma and carcinoid tumors [4, 7]. Unlike the juvenile type, adult granulosa cell tumor of the ovary has a characteristic coffee bean grooved and uniform nuclei in 30–60% of cases and often have an immunocytochemistry positive for inhibin [2, 8]. Histologically adult granulosa cell tumor pattern can vary. Some patterns that can make up the tumor include: microfollicular, diffuse, trabecular, macrofollicular, water silk, gyriform and insular patterns [2, 4].
In a study by Oranratanaphan et al., the synchronous primary endometrial and ovarian cancer group, patients were more likely to be younger, nulliparous and premenopausal compared with the metastatic group [9]. The most common presenting symptom for synchronous tumors was abnormal uterine bleeding [9]. Although in this case report the patient also presented with abnormal uterine bleeding, the patient was postmenopausal rather than pre-menopausal. Due to granulosa cell tumors of the ovary being associated with estradiol secretion they can present with endometrial pathology such as endometrial hyperplasia or endometrial carcinoma [10]. A retrospective study by Ottolina et al. revealed that 35.9% of symptomatic patients with adult granulosa cell tumor of the ovary also had endometrial pathology [10]. Some of the common presenting symptoms in Ottolina et al.’s study were abnormal bleeding, abdominal pain, pelvic pain, abdominal mass and abdominal distension [10]. Endometrial pathology most often presented in patients with adult granulosa cell tumor of the ovary who were 40 years of age or older [10].
A study by Moro et al. also confirmed that synchronous primary ovarian cancer is more likely to be unilateral and multilocular solid compared with the ovarian metastasis group [11]. Scully et al. pathologic criteria help distinguish between synchronous primary endometrial and ovarian cancer, and endometrial carcinoma with metastasis to the ovary [12]. For instance, criteria for ovarian metastasis encompasses: bilateral and multilocular tumors, deep myometrial invasion, invasion of vascular space in the myometrium, lack of ovarian endometriosis, spread has an endometrial carcinoma pattern, similar molecular genetics and location in the ovary is not hilar, in vascular space or surface implants [12]. These characteristics are absent in synchronous primary endometrial and ovarian tumors [12].
CONCLUSION
Not all patients with postmenopausal bleeding and endometrial carcinoma are necessarily presenting with metastasis if also presenting with an ovarian mass. Although uncommon, a diagnosis of synchronous granulosa cell tumor of the ovary and endometrial carcinoma is possible especially when considering that granulosa cell tumors of the ovary can be estradiol secreting and contribute to endometrial pathology.
CONFLICT OF INTEREST STATEMENT
There are no conflicts of interest.
FUNDING
None declared.